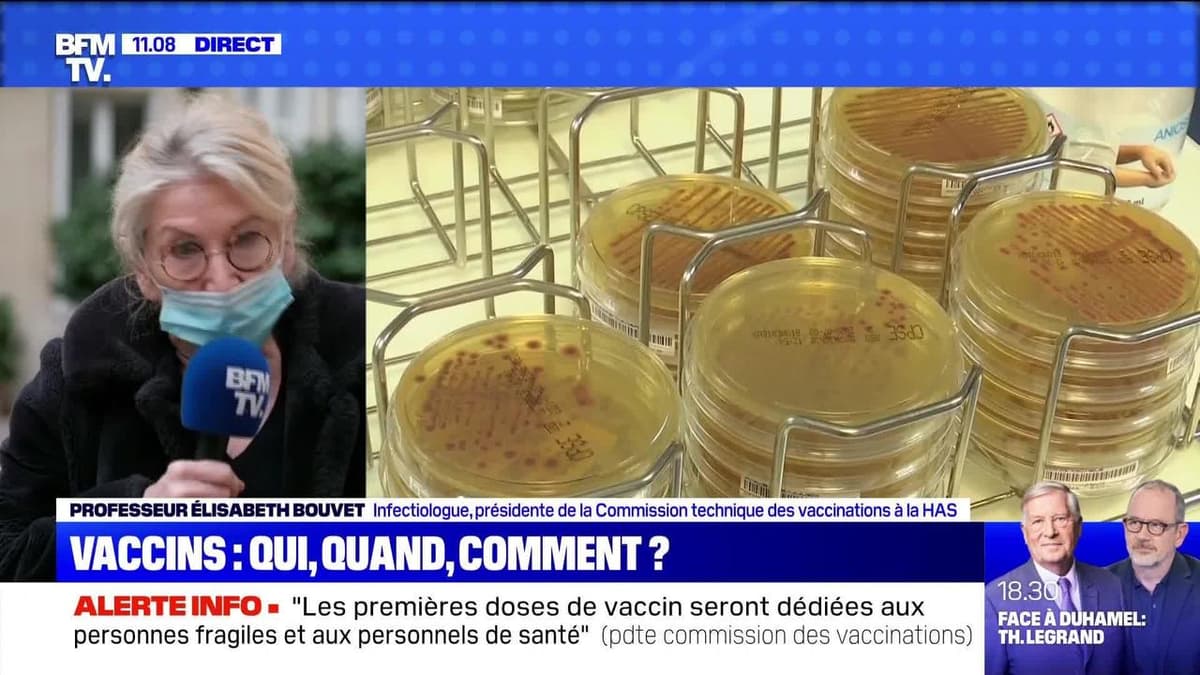

Vaccins : qui, quand, comment ? - 17/11
Le ministre de la Santé a évoqué ce mardi le début d'une campagne de vaccination contre le Covid au début de l'année 2021. Alors que la course aux vaccins se poursuit, Olivier Véran, interrogé sur BFMTV-RMC, a assuré qu'"il ne fera pas courir un risque aux Français". Sommes-nous en capacité de mettre en œuvre cette campagne ? Est-ce logique ou plutôt rapide ? - Avec: Professeur Elisabeth Bouvet, infectiologue et présidente de la Commission technique des vaccinations à la HAS. – Le Live Toussaint, du mardi 17 novembre 2020, sur BFMTV.
Chaque matin, Ronald Guintrange prend le temps de s’arrêter sur certains événements de l'actualité du jour. Un moment de pédagogie et d’explications à l'aide de reportages et d’éléments visuels pour prendre du recul sur les faits et permettre aux téléspectateurs de mieux
comprendre les événements.
BFMTV, 1ère chaîne d’information en continu de France, vous propose toute l’info en temps réel avec 18h d’antenne live par jour et des directs partout à travers le monde où l'actualité le nécessite. BFMTV, c'est aussi les débats et les grands reportages d'actualité. Retrouvez BFMTV sur le canal 15 de la TNT et sur BFMTV.com.
| Durée : 7:51